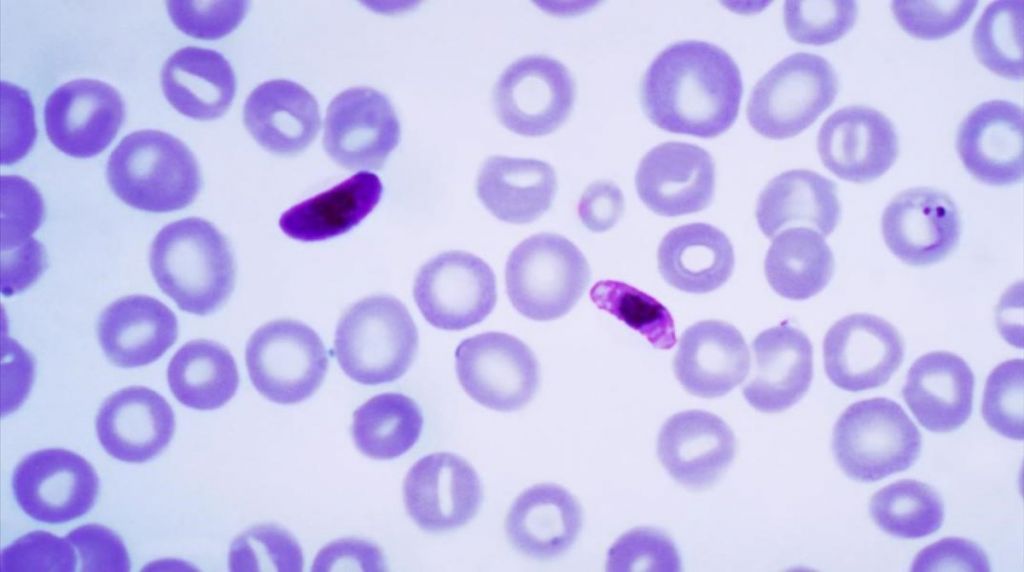

Aunque a día de hoy toda la carne y todo el pescado que compramos, parece que son seguros, no es así. Algunas veces portan en su interior ciertos parásitos como los anisakis que nos pueden afectar mucho. Sobre todo, la carne de caza sin haber pasado por una revisión veterinaria y el pescado crudo sin congelar pueden llegar a ser muy peligrosos.
De hecho, durante el año pasado, un grupo de cazadores decidió hacer embutido de la carne de 5 jabalíes que habían capturado durante una salida. Por supuesto que esto lo realizaron sin ningún tipo de inspección veterinaria. Estos animales tenían un parásito llamado triquina que afectó tanto a los cazadores como a sus familias, ya que repartieron el embutido y provocaron 13 casos de triquinosis.
5Toxoplasma
Este parásito es de extrema preocupación sobre todo para las embarazadas. Este protozoo es un ser vivo unicelular pero que puede tener distintos ciclos de vida. Este Toxoplasma concretamente se puede encontrar en las heces de cualquier felino y en la carne no cocinada de animales parasitados.
El ser humano está ampliamente infectado con Toxoplasma, de hecho, cerca de la mitad de la población mundial tiene quistes en el cerebro procedentes de este parásito. En Francia, donde la comida cruda es un habitual de su dieta, se presume que el porcentaje de infectados por toxoplasma puede llegar al 90%. Son datos que no tienen demasiada importancia debido a que apenas hay síntomas. Pero las personas con defensas bajas y las embarazadas que entran en contacto con el protozoo por primera vez si pueden tener problemas.
